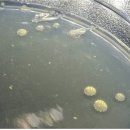
한천 이미지

한천 총54명이 열람하였으며, 0개의 리뷰가 있습니다.
- 하천코드
- 10
- 하천명
- 한천
- 제1지류명
- 미호강
- 제2지류명
- 한천
- 하천구분명
- 지방하천
- 하천지정근거명
- 하천법
- 시점위치
- 충청북도 음성군 경계
- 종점위치
- 충청북도 진천군 초평면 오갑리 미호강 합류점
- 시점위치(위도)
- 37
- 종점위치(위도)
- 37
- 시점위치(경도)
- 128
- 종점위치(경도)
- 128
- 하천길이
- 8
- 관리기관명
- 충청북도 진천군
- 관리기관전화번호
- 043-539-4274
- 데이터기준일자
- 2024-12-20
- 제공기관코드
- 4,450,000
- 제공기관명
- 충청북도 진천군
- 전화번호
블로그 리뷰
-
하늘이 유난히 맑고 깨끗한 주말 아이들과 함께 재미있는 체험도 하고 새로운 것도 배울 수 있는 약간은 생소하면서 흥미로운 곳, 밀양 한천 테마파크를 찾았습니다. 밀양한천테마파크 경상남도 밀양시 산내면 봉의로 58-31 밀양한천 테마파크 들어가는 입구 좌측의 드넓은 들판이 한겨울에는 한천을 말리는 작업장...
내만내먹 홈베이킹 레시피(2026-04-08 09:19:00)

-
얼음골 케이블카 타러온김에 근처에있는 한천박물관도 다녀왔습니다 한천이 뭐지.... 했는데 한천에 대해 알게되었던 좋은시간 한천박물관 밀양한천테마파크 경상남도 밀양시 산내면 봉의로 58-31 밀양한천 테마파크 레스토랑 마중 경상남도 밀양시 산내면 봉의로 58-10 한천박물관은 역시나 밀양 산내면에 위치하고...
하니자몽클럽(2026-03-04 15:01:00)

-
다음에는 다른 제철 과일도 같이 썰어서 굳혀볼까해요! 아이 간식 고민하시는 분들께 도움 되었으면 좋겠어요 :) 내돈내산 솔직 후기였습니다. ▼▼▼ 제품 자세히 보기 가격과 후기 확인 가능합니다. 필요하신 분들은 아래 링크 참고하세요. 밀양한천 컵젤리 믹스, 296g, 1세트 - 츄잉젤리 | 쿠팡 쿠팡에서 밀양...
엄마의 돈벌기 실험실(2026-03-30 09:36:00)

-
한천자연휴양림 캠핑장은 정확한 캠핑장 정보가 많지 않아 직접 다녀와봤습니다. 📍 한천자연휴영림 위치 & 정보 한천자연휴양림캠핑장 전라남도 화순군 한천면 죽헌로 723 가격은 : 18,000원 시간은 : 14:00 ~ 11:00 애완동물은 반입이 안돼요 ㅠ 매너 타임 : 저녁 10시 ~ 아침 7시 예약 은 자연휴양림 사이트에서 하실...
솔캠핑(2025-12-25 22:19:00)

-
종종 집에 들어오는 선물세트 중 가장 맘에 들고 좋아하는 품목! 바로 밀양한천 양갱선물세트! 받아보고 먹어보고 만족으로 추천하는 찐후기입니당! (밀양한천)명품양갱종합세트 4호 양갱 선물 세트 할머니간식 : 제주사람이 팝니다 제주사람이 팝니다 naver.me 정겨운 우리 명절, 전통 간식으로 의미에 센스까지! 우리...
For My Memory, For Your Information.(2026-01-25 09:20:00)

-
밀양한천 명품 통팥양갱 솔직 후기 먹어보니 이런 맛이었습니다 혹시 양갱 좋아하시나요? 요즘 카페 디저트가 워낙 많다 보니 의외로 전통 간식인 양갱을 찾는 분들도 꽤 많습니다. 저도 최근에 내돈내산으로 구입한 밀양한천 명품 통팥양갱을 먹어봤는데 생각보다 팥 맛이 진하고 식감이 괜찮아서 인상적이었습니다...
검정깍두기님의 블로그(2026-03-09 23:03:00)

-
안녕하세요 ◡̈ 오늘은 분위기도 좋고, 야들한 족발에 한잔하기 좋은 천안 불당동 족발 맛집 “오밤족”을 소개해드릴게요 💓 ✨오밤족✨ 📍주소 충남 천안시 서북구 불당동 1492 ⏰영업시간 15:00 ~ 23:00 정기휴무 - 일요일 ☎️ 전화번호 0507-1334-9706 오밤족 천안불당점 충청남도 천안시 서북구 불당26로 144 근린생활시설...
쩝쩝박사의_냠냠노트 ෆ(2026-03-25 08:30:00)

-
자연과 함께하는 오감만족 한천빌리지 5살 아이랑 다녀온 후기 안녕하세요! 이번에 아기랑 화순 다녀왔어요! 자연생태체험 할 수 있는 한천빌리지! 유아부터 초등학생들이 재미있는 체험학습을 할 수 있는 프로그램 체험장이에요. #화순아기랑 #광주근교아기랑가볼만한곳 #한천빌리지 #화순한천빌리지 #전남아기랑여행...
핫플사냥꾼 오백마마(2025-08-25 10:07:00)

-
휴일이... 너무 길고 길었던 추석연휴 친구들과 미리 예약해서 방문한 화순"한천빌리지" 첫째는 이제는 자연... 생태 체험같은 걸 시시해 하는 터라 둘째만 데리고 출발함 가는 날 날씨가 너무 좋네.... 오랜만에 외동모드로 엄마와 데이트 하는 둘째는 매우 신났고 맑은 하늘에 나도 매우 신났쥐 화순 "한천빌리지...
그냥 쓰는 blog(2025-10-31 16:30:00)

-
도심의 소음이 멀리 느껴질 만큼 조용한 숲속에서 하룻밤을 보내고 싶어 전남 화순에 있는 한천자연휴양림 캠핑장으로 솔캠을 다녀왔습니다. 오늘은 감성 가득했던 한천자연휴양림 캠핑장 솔캠 후기를 남기면서 사이트 구성과 편의시설 등 실제 이용 정보도 함께 정리해 보겠습니다. 화순 한천자연휴양림 캠핑장...
곰세마리 라이프(2025-11-01 16:19:00)

일별 방문 통계
월별 방문 통계
날씨
리뷰 (0)
등록된 리뷰가 없습니다.
첨부파일